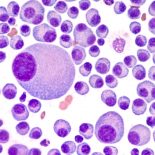

ESMO Congress
We cover the most interesting news from the ESMO Congress through abstracts, online articles and MEDtalk videos from experts and specialists worldwide.
Go to pageLung cancer site
Visit our lung cancer site
and stay updated on the latest research
*BestPractice Nordic maintains a continuous dialogue with the Nordic Advisory Editorial Panel. This panel aids in proposing editorial themes, bringing attention to new guidelines, essays, relevant clinical issues, and updates from national and international congresses. Please note that the advisory editorial panel is NOT accountable for the content published by BestPractice Nordic. All content undergoes approval by the author.
Read the latest magazine
Oncology / Hematology • No. 18 • 2025
- Highlights From the Nordic Urothelial Cancer Oncology Group
- CAR-T Will Transform the Treatment of Malignant Diseases
- Advancing Myeloma Research and Treatment